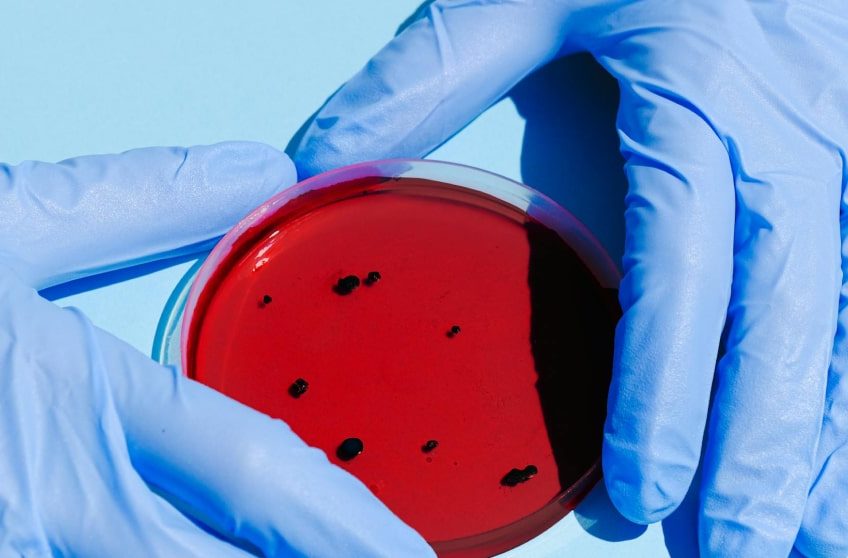
portfolio10-min portfolio10-min

The Guidelines and Challenges of Performing NHP DART Studies
At its annual Quantum Summit in New York, IBM unveiled its quantum roadmap for both hardware and software through the next 10 years. It represents a continuation of the roadmaps they have presented but also promises a disruptive leap for 2024.
Read More
The convergence of nuclear medicine and pediatric orthopedic surgery
In pediatrics, young patients may not be able to communicate the exact location and intensity of the pain they’re experiencing. With SPECT/CT the origin of pain becomes clearly visible, which can lead to more accurate diagnoses.
Read More
New antigen tests are worse than PCR for evaluating asymptomatic patients
One of the leading companies in the sector warns that they tend to give false negatives in people with lower amounts of virus and point out that they are only reliable in those with high viral load
Read More
IBM Quantum Summit 2020: Exploring the Promise of Quantum Computing for Industry
A recent panel discussion on “The Promise of Quantum for Industry” at the annual IBM Quantum Summit homed in on several business challenges that quantum computers are well-suited to tackle and more.
Read More
- 1
- 2
about us
Lorem ipsum dolor sit amet, consec tet cing elit, sed do eiusmod tempor inc ididunt utore et dolore magna aliqua. Ut enim ad minim veniam erc.
categories
- Molecular Biology (2)
- Pathology (5)
- Pediatric (3)
- Research (6)
- Uncategorized (1)